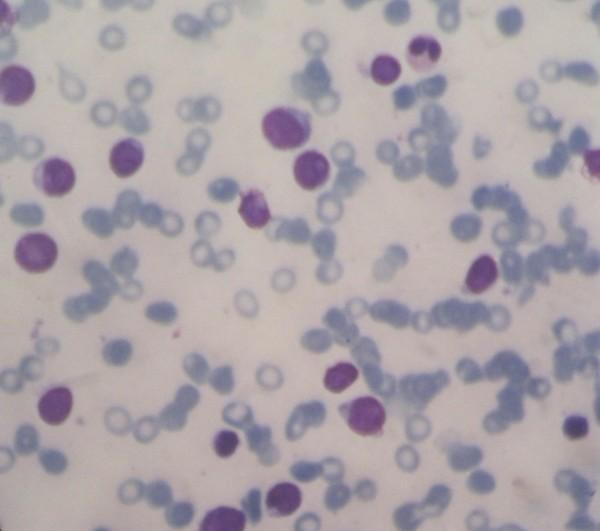

一名7岁男孩急性淋巴细胞白血病所致骨质疏松:病例报告
Osteoporosis resulting from acute lymphoblastic leukemia in a 7-year-old boy: a case report.
作者信息
Salim Hendra, Ariawati Ketut, Suryawan Wayan Bikin, Arimbawa Made
机构信息
Division of Hematology and Oncology, Department of Child Health, Medical Faculty of Udayana University, Sanglah Hospital, Kesehatan Street No, 1, Denpasar, Bali, Indonesia.
出版信息
J Med Case Rep. 2014 May 28;8:168. doi: 10.1186/1752-1947-8-168.
INTRODUCTION
Osteoporosis in children is rare and usually secondary to an underlying disease process whose diagnosis may be difficult to detect. Etiological factors responsible for osteoporosis secondary to chronic illness include immobility, pubertal delay and other hormonal disturbances. Rarely, it can be a manifestation of acute lymphoblastic leukemia. Most of the reported bone fracture incidences associated with acute lymphoblastic leukemia occur during the course of the chemotherapy, not at the point of the first symptoms of leukemic disease, as happened with the case presented here.
CASE PRESENTATION
A 7-year-old Asian Balinese boy presented with back pain. His anteroposterior pelvic radiograph showed osteoporotic bone. A bone age study revealed growth failure of his metacarpals, phalanges and sesamoid. His total bone mass density was 97% age-match. However, a peripheral blood smear showed normochromic anemia with thrombocytopenia. Immunophenotyping of his peripheral blood revealed no dominant markers, but a bone marrow aspiration confirmed a diagnosis of acute lymphoblastic leukemia.
CONCLUSIONS
Osteoporosis was the only manifestation of the child's underlying acute lymphoblastic leukemia. Leukemia was diagnosed when his bone marrow was found to contain more than 25% blasts. Because of leucopenia, the immunophenotype failed to reveal a dominant marker in this case, thus we were unable to classify the acute lymphoblastic leukemia.
引言
儿童骨质疏松症较为罕见,通常继发于某种潜在疾病过程,其诊断可能难以察觉。导致慢性病继发骨质疏松症的病因包括活动受限、青春期延迟和其他激素紊乱。极少数情况下,它可能是急性淋巴细胞白血病的一种表现。大多数报道的与急性淋巴细胞白血病相关的骨折发生率发生在化疗过程中,而非白血病疾病首发症状出现时,就像此处所呈现的病例那样。
病例介绍
一名7岁的亚洲巴厘岛男孩因背痛前来就诊。他的骨盆前后位X线片显示骨质疏松。骨龄研究显示其掌骨、指骨和籽骨生长发育迟缓。他的总骨密度为年龄匹配值的97%。然而,外周血涂片显示正色素性贫血伴血小板减少。其外周血免疫表型分析未发现优势标志物,但骨髓穿刺确诊为急性淋巴细胞白血病。
结论
骨质疏松症是该患儿潜在急性淋巴细胞白血病的唯一表现。当发现其骨髓中原始细胞超过25%时,白血病得以确诊。由于白细胞减少,该病例的免疫表型未能显示出优势标志物,因此我们无法对急性淋巴细胞白血病进行分类。